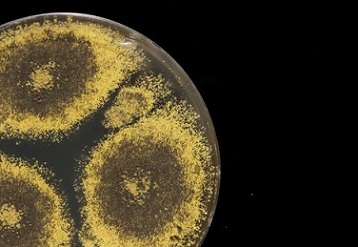
A culture of Eurotium herbariorum fungus, often retrieved from ocean-floor sediments.Credit: Tom Kleindinst/Woods Hole Oceanographic Institution (WHOI)

At the bottom of the Indian Ocean, in one of the deepest layers of Earth’s crust ever explored, researchers are finding life. An analysis of rock samples from Atlantis Bank, part of a seafloor mountain where deep crustal rock is exposed close to the surface, has revealed microbes adapted to life within nutrient-poor, hairline fractures in the earth.









